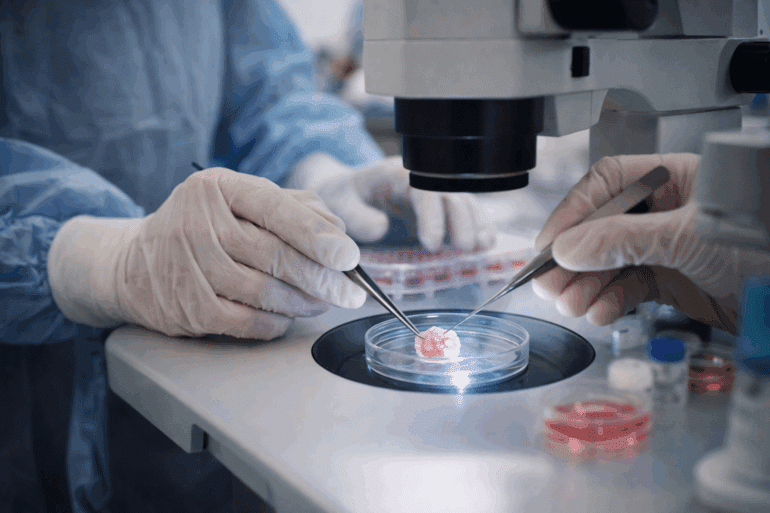

Om dit onderdeel te bekijken moet je ingelogd zijn of je kunt als BIG geregistreerde professional een gratis basis account aanmaken. Ben je niet BIG geregistreerd, dan kun je hieronder uit een van onze abonnementen kiezen.
Elke ingeschreven (huis)arts wordt volgens het BIG register gecontroleerd. HuisartsVandaag is ontwikkeld en wordt onderhouden door een team van huisartsen.
Nog geen account en BIG geregistreerd? Maak een gratis basis account aan!
Ook onbeperkt premium lezen?
Business Premium
5,77per week
- Met én zonder BIG
- Toegang tot alle artikelen
- Voor uzelf en 5 collega’s, medewerkers één abonnement
- Nodig zelf uw collega’s, medewerkers uit
- Eén jaarlijkse factuur
Premium Maandelijks
3,34per week
- Uitsluitend met BIG registratie
- Toegang tot alle artikelen
- Help ons u relevant nieuws te brengen
- Automatische maandelijkse afschrijving
- Looptijd 12 maanden
Premium Jaarlijks
2,77per week
- Uitsluitend met BIG registratie
- Toegang tot alle artikelen
- Help ons u het nieuwste nieuws te brengen
- Eén jaarlijkse factuur
- 2 maanden gratis